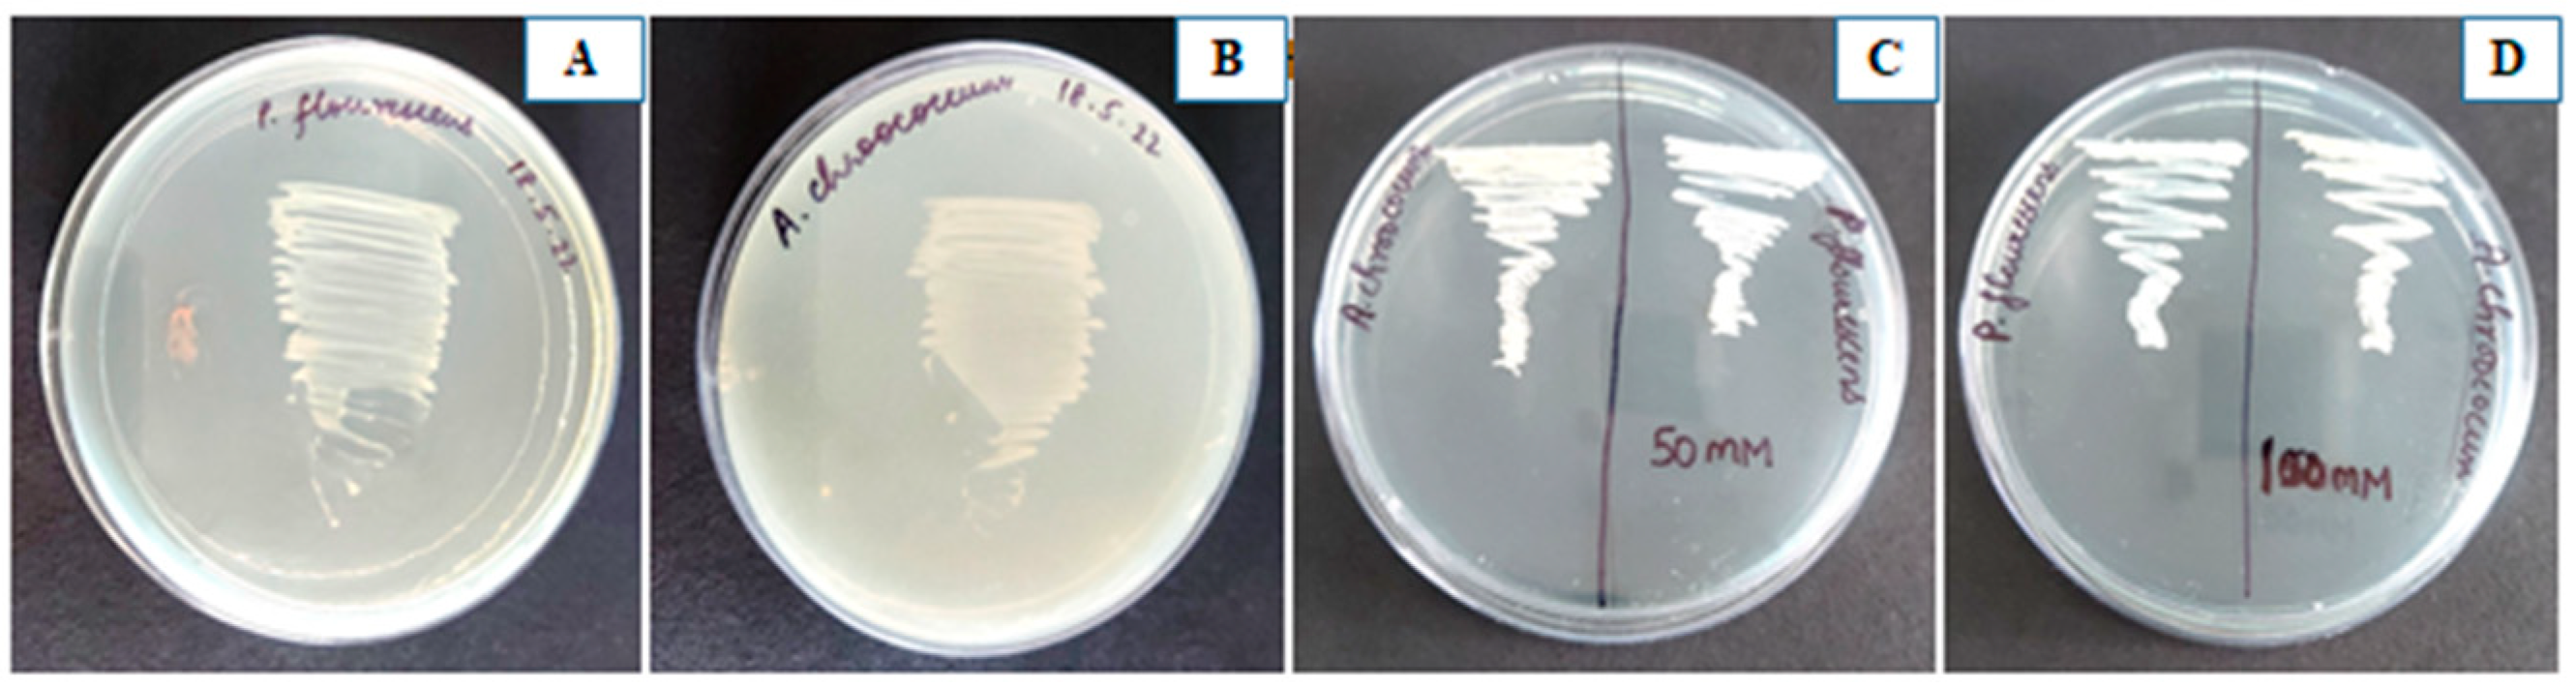
Plants 12 00705 g001

Palliating Salt Stress in Mustard through Plant-Growth-Promoting Rhizobacteria: Regulation of Secondary Metabolites, Osmolytes, Antioxidative Enzymes and Stress Ethylene
Abstract
1. Introduction
2. Materials and Methods
2.1. Plant Material and Growth Conditions
2.2. Procurement of Bacterial Strains
2.3. Inoculation of PGPR, NaCl Treatment and Experimental Design
2.4. Study of Plant-Growth-Promoting Attributes of Bacterial Strains
2.4.1. Indole Acetic Acid (IAA), ACC Deaminase and Siderophore Production
2.4.2. Ammonia Production, HCN Production and Phosphate Solubilization
2.5. Analysis of Morphological Parameters
2.6. Biochemical Parameters
2.6.1. Determination of Photosynthetic Parameters and Soluble Protein
2.6.2. Estimation of Proline, Total Soluble Sugar and Glycinebetaine
2.6.3. Estimation of Phenol, Flavonoid, Carotenoids and Glucosinolate Content
2.6.4. Estimation of Antioxidant Enzymes
Enzyme Extraction
Antioxidative Enzymes
Content of Reduced Glutathione
2.7. Determination of Lipid Peroxidation and H2O2 Content and Ethylene Evolution
2.8. Cellular Damage Detection and Viability Measurement in Mustard Roots Using Confocal Laser Scanning Microscopy
2.9. Determination of Visible Leaf Damage via Superoxide through Histochemical Staining
2.10. Compatibility Assay
2.11. Salt Tolerance Assay for PGPR Strains
2.12. Statistical Analysis
3. Results
3.1. Properties of Pseudomonas fluorescens and Azotobacter chroococcum
3.2. Application of PGPR Strains alleviated Growth Characteristics under Salt Stress
3.3. Impact of PGPR on Photosynthetic Pigments
3.4. Gas Exchange Parameters
3.5. Osmolytes Accumulation Increased under Salt Stress and Helped in Stress Tolerance
3.6. Impact on Total Phenol, Total Flavonoid, Carotenoids and Total Glucosinolate Content
3.7. Impact of PGPR on Lipid Peroxidation and H2O2 Content and Ethylene Evolution
3.8. Alleviating Effect of PGPR on Antioxidative Enzymes and GSH
3.9. Cellular Damage to Mustard Roots under Salt Stress as Determined via CLSM and Overcoming the Damage Using PGPR
3.10. Visible Damage Due to Superoxide Formation in Salt-Stressed Leaves and Its Alleviation Using PGPR
3.11. Synergism between Two PGPR
3.12. Principal Component Analysis
3.13. Pearson Correlation
4. Discussion
4.1. Impact of Combined PGPR on Mustard Morphological Characteristics under Salt Stress
4.2. Impact of PGPR on Photosynthetic Traits in Mustard under Salt Stress
4.3. PGPR in Combination Maximally Alleviated Oxidative Stress through an Increase in Antioxidative Enzymes and Antioxidant GSH
4.4. PGPR When Applied Together Maximally Increased Osmolytes Accumulation to Protect against Salt-Induced Osmotic Stress
4.5. PGPR Application Reduced Ethylene Evolution under Salt Stress and Maximally When Supplemented in Combination
4.6. PGPR Application Enhanced Secondary Metabolite Production but Decreased Glucosinolate Content under Salt Stress
5. Conclusions
Supplementary Materials
Author Contributions
Funding
Data Availability Statement
Acknowledgments
Conflicts of Interest
References
- Bera, K.; Dutta, P.; Sadhukhan, S. Plant responses under abiotic stress and mitigation options towards agricultural sustainability. In Plant Stress: Challenges and Management in the New Decade; Roy, S., Mathur, P., Chakraborty, A.P., Saha, S.P., Eds.; Springer: Cham, Switzerland, 2022; pp. 3–28. [Google Scholar]
- Shahid, S.A.; Zaman, M.; Heng, L. Soil salinity: Historical perspectives and a world overview of the problem. In Guideline for Salinity Assessment, Mitigation and Adaptation Using Nuclear and Related Techniques; Springer: Cham, Switzerland, 2018; pp. 43–53. [Google Scholar]
- Singh, V.K.; Singh, B.D.; Kumar, A.; Maurya, S.; Krishnan, S.G.; Vinod, K.K.; Singh, M.P.; Ellur, R.K.; Bhowmick, P.K.; Singh, A.K. Marker-assisted introgression of Saltol QTL enhances seedling stage salt tolerance in the rice variety “Pusa Basmati 1”. Int. J. Genom. 2018, 2018, 8319879. [Google Scholar] [CrossRef] [PubMed]
- Wani, A.S.; Ahmad, A.; Hayat, S.; Tahir, I. Epibrassinolide and proline alleviate the photosynthetic and yield inhibition under salt stress by acting on antioxidant system in mustard. Plant Physiol. Biochem. 2019, 135, 385–394. [Google Scholar] [CrossRef] [PubMed]
- Zhang, Q.; Dai, W. Plant response to salinity stress. In Stress Physiology of Woody Plants; CRC Press: Boca Raton, FL, USA, 2019; pp. 155–173. [Google Scholar]
- Zeeshan, M.; Lu, M.; Sehar, S.; Holford, P.; Wu, F. Comparison of biochemical, anatomical, morphological, and physiological responses to salinity stress in wheat and barley genotypes deferring in salinity tolerance. Agronomy 2020, 10, 127. [Google Scholar] [CrossRef]
- Pan, J.; Peng, F.; Tedeschi, A.; Xue, X.; Wang, T.; Liao, J.; Zhang, W.; Huang, C. Do halophytes and glycophytes differ in their interactions with arbuscular mycorrhizal fungi under salt stress? A meta-analysis. Bot. Stud. 2020, 61, 13. [Google Scholar] [CrossRef]
- Kerchev, P.I.; Van Breusegem, F. Improving oxidative stress resilience in plants. Plant J. 2022, 109, 359–372. [Google Scholar] [CrossRef]
- Dolatabadian, A.; Sanavy, S.M.; Chashmi, N.A. The effects of foliar application of ascorbic acid (vitamin C) on antioxidant enzymes activities, lipid peroxidation and proline accumulation of canola (Brassica napus L.) under conditions of salt stress. J. Agron. Crop. Sci. 2008, 194, 206–213. [Google Scholar] [CrossRef]
- Khan, N.A.; Nazar, R.; Anjum, N.A. Growth, photosynthesis and antioxidant metabolism in mustard (Brassica juncea L.) cultivars differing in ATP-sulfurylase activity under salinity stress. Sci. Hortic. 2009, 122, 455–460. [Google Scholar] [CrossRef]
- Falcinelli, B.; Sileoni, V.; Marconi, O.; Perretti, G.; Quinet, M.; Lutts, S.; Benincasa, P. Germination under moderate salinity increases phenolic content and antioxidant activity in rapeseed (Brassica napus var oleifera Del.) sprouts. Molecules 2017, 22, 1377. [Google Scholar] [CrossRef]
- Ekinci, M.; Yildirim, E.; Dursun, A.; Turan, M. Mitigation of salt stress in lettuce (Lactuca sativa L. var. Crispa) by seed and foliar 24-epibrassinolide treatments. HortScience 2012, 47, 631–636. [Google Scholar] [CrossRef]
- Arbona, V.; López-Climent, M.F.; Mahouachi, J.; Pérez-Clemente, R.M.; Abrams, S.R.; Gomez-Cadenas, A. Use of persistent analogs of abscisic acid as palliatives against salt-stress induced damage in citrus plants. J. Plant Growth Regul. 2006, 25, 1–9. [Google Scholar] [CrossRef]
- Rady, M.M. A novel organo-mineral fertilizer can mitigate salinity stress effects for tomato production on reclaimed saline soil. S. Afr. J. Bot. 2012, 81, 8–14. [Google Scholar] [CrossRef]
- Zhou, Y.; Wen, Z.; Zhang, J.; Chen, X.; Cui, J.; Xu, W.; Liu, H.Y. Exogenous glutathione alleviates salt-induced oxidative stress in tomato seedlings by regulating glutathione metabolism, redox status, and the antioxidant system. Sci. Hortic. 2017, 220, 90–101. [Google Scholar] [CrossRef]
- Vives-Peris, V.; Gómez-Cadenas, A.; Pérez-Clemente, R.M. Salt stress alleviation in citrus plants by plant growth-promoting rhizobacteria Pseudomonas putida and Novosphin gobium sp. Plant Cell Rep. 2018, 37, 1557–1569. [Google Scholar] [CrossRef] [PubMed]
- Qin, Y.; Druzhinina, I.S.; Pan, X.; Yuan, Z. Microbially mediated plant salt tolerance and microbiome-based solutions for saline agriculture. Biotechnol. Adv. 2016, 34, 1245–1259. [Google Scholar] [CrossRef]
- Rosenblueth, M.; Ormeño-Orrillo, E.; López-López, A.; Rogel, M.A.; Reyes-Hernández, B.J.; Martínez-Romero, J.C.; Reddy, P.M.; Martínez-Romero, E. Nitrogen fixation in cereals. Front Microbiol. 2018, 9, 1794. [Google Scholar] [CrossRef]
- Tandon, A.; Fatima, T.; Shukla, D.; Tripathi, P.; Srivastava, S.; Singh, P.C. Phosphate solubilization by Trichoderma koningiopsis (NBRI-PR5) under abiotic stress conditions. J. King Saud Univ. Sci. 2020, 32, 791–798. [Google Scholar] [CrossRef]
- Xiao, Y.; Wang, X.; Chen, W.; Huang, Q. Isolation and identification of three potassium-solubilizing bacteria from rape rhizospheric soil and their effects on ryegrass. Geomicrobiol. J. 2017, 34, 873–880. [Google Scholar] [CrossRef]
- Sarwar, N.; Akhtar, M.; Kamran, M.A.; Imran, M.; Riaz, M.A.; Kamran, K.; Hussain, S. Selenium biofortification in food crops: Key mechanisms and future perspectives. J. Food Compos. Anal. 2020, 93, 103615. [Google Scholar] [CrossRef]
- Cassán, F.; Vanderleyden, J.; Spaepen, S. Physiological and agronomical aspects of phytohormone production by model plant-growth-promoting rhizobacteria (PGPR) belonging to the genus Azospirillum. J. Plant Growth Regul. 2014, 33, 440–459. [Google Scholar] [CrossRef]
- Vacheron, J.; Desbrosses, G.; Bouffaud, M.L.; Touraine, B.; Moënne-Loccoz, Y.; Muller, D.; Legendre, L.; Wisniewski-Dyé, F.; Prigent-Combaret, C. Plant growth-promoting rhizobacteria and root system functioning. Front. Plant Sci. 2013, 4, 356. [Google Scholar] [CrossRef]
- Singh, R.P.; Jha, P.; Jha, P.N. The plant-growth-promoting bacterium Klebsiella sp. SBP-8 confers induced systemic tolerance in wheat (Triticum aestivum) under salt stress. J. Plant Physiol. 2015, 184, 57–67. [Google Scholar] [CrossRef] [PubMed]
- Nadeem, S.M.; Ahmad, M.; Naveed, M.; Imran, M.; Zahir, Z.A.; Crowley, D.E. Relationship between in vitro characterization and comparative efficacy of plant growth-promoting rhizobacteria for improving cucumber salt tolerance. Arch. Microbiol. 2016, 198, 379–387. [Google Scholar] [CrossRef] [PubMed]
- Lin, L.Z.; Sun, J.; Chen, P.; Harnly, J. UHPLC-PDA-ESI/HRMS/MS n analysis of anthocyanins, flavonol glycosides, and hydroxycinnamic acid derivatives in red mustard greens (Brassica juncea Coss variety). J. Agric. Food Chem. 2011, 59, 12059–12072. [Google Scholar] [CrossRef]
- Lim, S.H.; Yoo, E.J.; Choi, M.R. Changes of physiological activity of mustard leaf during its fermentation period. J. Microbiol. Biotechnol. 2000, 10, 43–47. [Google Scholar]
- Campbell, B.; Han, D.; Triggs, C.M.; Fraser, A.G.; Ferguson, L.R. Brassicaceae: Nutrient analysis and investigation of tolerability in people with Crohn’s disease in a New Zealand study. Funct. Foods Health Dis. 2012, 2, 460–486. [Google Scholar] [CrossRef]
- Jaiswal, S.K.; Prakash, R.; Acharya, R.; Reddy, A.V.; Prakash, N.T. Selenium content in seed, oil and oil cake of Se hyperaccumulated Brassica juncea (Indian mustard) cultivated in a seleniferous region of India. Food Chem. 2012, 134, 401–404. [Google Scholar] [CrossRef]
- Mandal, K.G.; Hati, K.M.; Misra, A.K.; Bandyopadhyay, K.K. Root biomass, crop response and water-yield relationship of mustard (Brassica juncea L.) grown under combinations of irrigation and nutrient application. Irrig. Sci. 2010, 28, 271–280. [Google Scholar] [CrossRef]
- Azizoglu, U. Bacillus thuringiensis as a biofertilizer and biostimulator: A mini-review of the little-known plant growth-promoting properties of Bt. Curr. Microbiol. 2019, 76, 1379–1385. [Google Scholar] [CrossRef]
- Bric, J.M.; Bostock, R.M.; Silverstone, S.E. Rapid in situ assay for indoleacetic acid production by bacteria immobilized on a nitrocellulose membrane. Appl. Environ. Microbiol. 1991, 57, 535–538. [Google Scholar] [CrossRef]
- Penrose, D.M.; Glick, B.R. Methods for isolating and characterizing ACC deaminase-containing plant growth-promoting rhizobacteria. Physiol. Plant. 2003, 118, 10–15. [Google Scholar] [CrossRef]
- Alexander, D.B.; Zuberer, D.A. Use of chrome azurol S reagents to evaluate siderophore production by rhizosphere bacteria. Biol. Fertil. Soils. 1991, 12, 39–45. [Google Scholar] [CrossRef]
- Cappuccino, J.G.; Sherman, N. Biochemical activities of microorganisms. In Microbiology, A Laboratory Manual; The Benjamin/Cummings Publishing: San Francisco, CA, USA, 1992; p. 76. [Google Scholar]
- Schippers, B.; Bakker, A.W.; Bakker, P.A. Interactions of deleterious and beneficial rhizosphere microorganisms and the effect of cropping practices. Annu. Rev. Phytopathol. 1987, 25, 339–358. [Google Scholar] [CrossRef]
- Pikovskaya, R.I. Mobilization of phosphorus in soil in connection with vital activity of some microbial species. Mikrobiologiya 1948, 17, 362–370. [Google Scholar]
- Sindhu, S.S.; Gupta, S.K.; Dadarwal, K.R. Antagonistic effect of Pseudomonas spp. on pathogenic fungi and enhancement of growth of green gram (Vigna radiata). Biol. Fertil. Soils. 1999, 29, 62–68. [Google Scholar] [CrossRef]
- Hiscox, J.D.; Israelstam, G.F. A method for the extraction of chlorophyll from leaf tissue without maceration. Canad. J. Bot. 1979, 57, 1332–1334. [Google Scholar] [CrossRef]
- Bradford, M.M. A rapid and sensitive method for the quantitation of microgram quantities of protein utilizing the principle of protein-dye binding. Anal. Biochem. 1976, 72, 248–254. [Google Scholar] [CrossRef]
- Bates, L.S.; Waldren, R.P.; Teare, I.D. Rapid determination of free proline for water-stress studies. Plant Soil 1973, 39, 205–207. [Google Scholar] [CrossRef]
- Dey, P.M. Oligosaccharides. In Methods in Plant Biochemistry; Academic Press: Cambridge, MA, USA, 1990; pp. 189–218. [Google Scholar]
- Grieve, C.M.; Grattan, S.R. Rapid assay for determination of water soluble quaternary ammonium compounds. Plant Soil 1983, 70, 303–307. [Google Scholar] [CrossRef]
- Ainsworth, E.A.; Gillespie, K.M. Estimation of total phenolic content and other oxidation substrates in plant tissues using Folin–Ciocalteu reagent. Nat. Protoc. 2007, 2, 875–877. [Google Scholar] [CrossRef]
- Kiddle, G.; Bennett, R.N.; Botting, N.P.; Davidson, N.E.; Robertson, A.A.; Wallsgrove, R.M. High-performance liquid chromatographic separation of natural and synthetic desulphoglucosinolates and their chemical validation by UV, NMR and chemical ionisation-MS methods. Phytochem. Anal. 2001, 12, 226–242. [Google Scholar] [CrossRef]
- Doheny-Adams, T.; Redeker, K.; Kittipol, V.; Bancroft, I.; Hartley, S.E. Development of an efficient glucosinolate extraction method. Plant Methods 2017, 13, 17. [Google Scholar] [CrossRef] [PubMed]
- Beauchamp, C.; Fridovich, I. Superoxide dismutase: Improved assays and an assay applicable to acrylamide gels. Anal. Biochem. 1971, 44, 276–287. [Google Scholar] [CrossRef] [PubMed]
- Beers, R.F.; Sizer, I.W. A spectrophotometric method for measuring the breakdown of hydrogen peroxide by catalase. J. Biol Chem. 1952, 195, 133–140. [Google Scholar] [CrossRef] [PubMed]
- Nakano, Y.; Asada, K. Hydrogen peroxide is scavenged by ascorbate-specific peroxidase in spinach chloroplasts. Plant Cell Physiol. 1981, 22, 867–880. [Google Scholar]
- Jablonski, P.P.; Anderson, J.W. Light-dependent reduction of oxidized glutathione by ruptured chloroplasts. Plant Physiol. 1978, 61, 221–225. [Google Scholar] [CrossRef]
- Anderson, M.E. Determination of glutathione and glutathione disulfide in biological samples. Meth. Enzymol. 1985, 113, 148–155. [Google Scholar]
- Zhou, W.J.; Leul, M. Uniconazole-induced alleviation of freezing injury in relation to changes in hormonal balance, enzyme activities and lipid peroxidation in winter rape. Plant Growth Regul. 1998, 26, 41–47. [Google Scholar] [CrossRef]
- Velikova, V.; Yordanov, I.; Edreva, A. Oxidative stress and some antioxidant systems in acid rain-treated bean plants: Protective role of exogenous polyamines. Plant Sci. 2000, 151, 59–66. [Google Scholar] [CrossRef]
- Sehar, Z.; Iqbal, N.; Khan, M.I.; Masood, A.; Rehman, M.; Hussain, A.; AlAjmi, M.F.; Ahmad, A.; Khan, N.A. Ethylene reduces glucose sensitivity and reverses photosynthetic repression through optimization of glutathione production in salt-stressed wheat (Triticum aestivum L.). Sci. Rep. 2021, 11, 12650. [Google Scholar] [CrossRef]
- Kumar, D.; Yusuf, M.A.; Singh, P.; Sardar, M.; Sarin, N.B. Histochemical detection of superoxide and H2O2 accumulation in Brassica juncea seedlings. Bio-Protoc. 2014, 20, e1108. [Google Scholar] [CrossRef]
- Sarkar, A.; Ghosh, P.K.; Pramanik, K.; Mitra, S.; Soren, T.; Pandey, S.; Mondal, M.H.; Maiti, T.K. A halotolerant Enterobacter sp. displaying ACC deaminase activity promotes rice seedling growth under salt stress. Microbiol. Res. 2018, 169, 20–32. [Google Scholar] [CrossRef] [PubMed]
- Shukla, P.S.; Agarwal, P.K.; Jha, B. Improved salinity tolerance of Arachis hypogaea (L.) by the interaction of halotolerant plant-growth-promoting rhizobacteria. J. Plant Growth Regul. 2012, 31, 195–206. [Google Scholar] [CrossRef]
- Khan, A.; Zhao, X.Q.; Javed, M.T.; Khan, K.S.; Bano, A.; Shen, R.F.; Masood, S. Bacillus pumilus enhances tolerance in rice (Oryza sativa L.) to combined stresses of NaCl and high boron due to limited uptake of Na+. Environ. Exp. Bot. 2016, 124, 120–129. [Google Scholar] [CrossRef]
- Wang, W.; Wu, Z.; He, Y.; Huang, Y.; Li, X.; Ye, B.C. Plant growth promotion and alleviation of salinity stress in Capsicum annuum L. by Bacillus isolated from saline soil in Xinjiang. Ecotoxicol. Environ. Saf. 2018, 164, 520–529. [Google Scholar] [CrossRef]
- Sapre, S.; Gontia-Mishra, I.; Tiwari, S. Klebsiella sp. confers enhanced tolerance to salinity and plant growth promotion in oat seedlings (Avena sativa). Microbiol. Res. 2018, 206, 25–32. [Google Scholar] [CrossRef]
- Win, K.T.; Tanaka, F.; Okazaki, K.; Ohwaki, Y. The ACC deaminase expressing endophyte Pseudomonas spp. Enhances NaCl stress tolerance by reducing stress-related ethylene production, resulting in improved growth, photosynthetic performance, and ionic balance in tomato plants. Plant Physiol. Biochem. 2018, 127, 599–607. [Google Scholar] [CrossRef]
- Rehman, B.; Hassan, T.U.; Bano, A. Potential of indole-3-acetic acid-producing rhizobacteria to resist Pb toxicity in polluted soil. Soil Sediment Contam. 2019, 28, 101–121. [Google Scholar] [CrossRef]
- Nayak, A.K.; Panda, S.S.; Basu, A.; Dhal, N.K. Enhancement of toxic Cr (VI), Fe, and other heavy metals phytoremediation by the synergistic combination of native Bacillus cereus strain and Vetiveria zizanioides L. Soil Sediment Contam. 2018, 20, 682–691. [Google Scholar] [CrossRef]
- Yasmin, H.; Nosheen, A.; Naz, R.; Bano, A.; Keyani, R. L-tryptophan-assisted PGPR-mediated induction of drought tolerance in maize (Zea mays L.). J. Plant Interact. 2017, 12, 567–578. [Google Scholar] [CrossRef]
- Kalaiarasi, R.; Dinakar, S. Positive effect of different formulations of Azotobacter and Paenibacillus on the enhancement of growth and yield parameters in maize (Zea mays L.). Int. J. Curr. Microbiol. Appl. Sci. 2015, 4, 190–196. [Google Scholar]
- Bakhshandeh, E.; Gholamhosseini, M.; Yaghoubian, Y.; Pirdashti, H. Plant growth promoting microorganisms can improve germination, seedling growth and potassium uptake of soybean under drought and salt stress. Plant Growth Regul. 2020, 90, 123–136. [Google Scholar] [CrossRef]
- Sarikhani, M.R.; Khoshru, B.; Greiner, R. Isolation and identification of temperature tolerant phosphate solubilizing bacteria as a potential microbial fertilizer. World J. Microbiol. Biotechnol. 2019, 35, 126. [Google Scholar] [CrossRef] [PubMed]
- Lally, R.D.; Galbally, P.; Moreira, A.S.; Spink, J.; Ryan, D.; Germaine, K.J.; Dowling, D.N. Application of endophytic Pseudomonas fluorescens and a bacterial consortium to Brassica napus can increase plant height and biomass under greenhouse and field conditions. Front. Plant Sci. 2017, 8, 2193. [Google Scholar] [CrossRef] [PubMed]
- Xiang, N.; Lawrence, K.S.; Kloepper, J.W.; Donald, P.A.; McInroy, J.A. Biological control of Heterodera glycines by spore-forming plant growth-promoting rhizobacteria (PGPR) on soybean. PLoS ONE 2017, 12, e0181201. [Google Scholar] [CrossRef] [PubMed]
- Ullah, U.; Ashraf, M.; Shahzad, S.M.; Siddiqui, A.R.; Piracha, M.A.; Suleman, M. Growth behavior of tomato (Solanum lycopersicum L.) under drought stress in the presence of silicon and plant growth promoting rhizobacteria. Soil Environ. 2016, 35, 65–75. [Google Scholar]
- Ali, S.Z.; Sandhya, V.; Venkateswar Rao, L. Isolation and characterization of drought-tolerant ACC deaminase and exopolysaccharide-producing fluorescent Pseudomonas sp. Ann. Microbiol. 2014, 64, 493–502. [Google Scholar] [CrossRef]
- Rizvi, A.; Khan, M.S. Heavy metal induced oxidative damage and root morphology alterations of maize (Zea mays L.) plants and stress mitigation by metal tolerant nitrogen fixing Azotobacter chroococcum. Ecotoxicol. Environ. Saf. 2018, 157, 9–20. [Google Scholar] [CrossRef]
- Ilangumaran, G.; Smith, D.L. Plant growth promoting rhizobacteria in amelioration of salinity stress: A systems biology perspective. Front. Plant Sci. 2017, 8, 1768. [Google Scholar] [CrossRef]
- Ahmad, M.; Zahir, Z.A.; Asghar, H.N.; Arshad, M. The combined application of rhizobial strains and plant growth promoting rhizobacteria improves growth and productivity of mung bean (Vigna radiata L.) under salt-stressed conditions. Ann. Microbiol. 2012, 62, 1321–1330. [Google Scholar] [CrossRef]
- Zaidi, P.H.; Rafique, S.; Rai, P.K.; Singh, N.N.; Srinivasan, G. Tolerance to excess moisture in maize (Zea mays L.): Susceptible crop stages and identification of tolerant genotypes. Field Crops Res. 2004, 90, 189–202. [Google Scholar] [CrossRef]
- Afzal, I.; Basra, S.A.; Iqbal, A. The effects of seed soaking with plant growth regulators on seedling vigor of wheat under salinity stress. J. Stress Physiol. Biochem. 2005, 1, 6–15. [Google Scholar]
- Spaepen, S.; Vanderleyden, J. Auxin and plant-microbe interactions. Cold Spring Harb. Perspect. Biol. 2011, 3, a001438. [Google Scholar]
- Dimkpa, C.; Svatoš, A.; Merten, D.; Büchel, G.; Kothe, E. Hydroxamate siderophores produced by Streptomyces acidiscabies E13 bind nickel and promote growth in cowpea (Vigna unguiculata L.) under nickel stress. Can. J. Microbiol. 2008, 54, 163–172. [Google Scholar] [CrossRef] [PubMed]
- Dimkpa, C.O.; Merten, D.; Svatoš, A.; Büchel, G.; Kothe, E. Siderophores mediate reduced and increased uptake of cadmium by Streptomyces tendae F4 and sunflower (Helianthus annuus), respectively. J. Appl. Microbiol. 2009, 107, 1687–1696. [Google Scholar] [CrossRef] [PubMed]
- Egamberdiyeva, D. The effect of plant growth promoting bacteria on growth and nutrient uptake of maize in two different soils. Appl. Soil Ecol. 2007, 36, 184–189. [Google Scholar] [CrossRef]
- Lukkani, N.J.; Reddy, E.S. Evaluation of plant growth promoting attributes and biocontrol potential of native fluorescent Pseudomonas spp. against Aspergillus niger causing collar rot of ground nut. Int. J. Plant Anim. Environ. Sci. 2014, 4, 256–262. [Google Scholar]
- Pick, U.; Chitlaru, E.; Weiss, M. Polyphosphate-hydrolysis-a protective mechanism against alkaline stress? FEBS Lett. 1990, 274, 15–18. [Google Scholar]
- Walters, R.G. Towards an understanding of photosynthetic acclimation. J. Exp. Bot. 2005, 56, 435–447. [Google Scholar] [CrossRef]
- Levitt, J. Responses of Plants to Environmental Stress, Volume 1: Chilling, Freezing, and High Temperature Stresses; Academic Press: Cambridge, MA, USA, 1980. [Google Scholar]
- Elkelish, A.A.; Soliman, M.H.; Alhaithloul, H.A.; El-Esawi, M.A. Selenium protects wheat seedlings against salt stress-mediated oxidative damage by up-regulating antioxidants and osmolytes metabolism. Plant Physiol. Biochem. 2019, 137, 144–153. [Google Scholar] [CrossRef]
- Ahanger, M.A.; Agarwal, R.M. Salinity stress induced alterations in antioxidant metabolism and nitrogen assimilation in wheat (Triticum aestivum L.) as influenced by potassium supplementation. Plant Physiol. Biochem. 2017, 115, 449–460. [Google Scholar] [CrossRef]
- Indiragandhi, P.; Anandham, R.; Madhaiyan, M.; Sa, T.M. Characterization of plant growth–promoting traits of bacteria isolated from larval guts of diamondback moth Plutella xylostella (Lepidoptera: Plutellidae). Curr. Microbiol. 2008, 56, 327–333. [Google Scholar] [CrossRef] [PubMed]
- Rajkumar, M.; Ae, N.; Prasad, M.N.; Freitas, H. Potential of siderophore-producing bacteria for improving heavy metal phytoextraction. Trends Biotechnol. 2010, 28, 142–149. [Google Scholar] [CrossRef] [PubMed]
- Figueiredo, M.D.; Seldin, L.; Araujo, F.F.; Mariano, R.D. Plant growth promoting rhizobacteria: Fundamentals and applications. In Plant Growth and Health Promoting Bacteria; Springer: Berlin/Heidelberg, Germany, 2010; pp. 21–43. [Google Scholar]
- Rabiei, Z.; Hosseini, S.J.; Pirdashti, H.; Hazrati, S. Physiological and biochemical traits in coriander affected by plant growth-promoting rhizobacteria under salt stress. Heliyon 2020, 6, e05321. [Google Scholar] [CrossRef] [PubMed]
- Gupta, S.; Gupta, K.; Nehra, C.; Gaur, R.K.; Yadav, D. Biotechnological Intervention for Sugarcane Improvement Under Salinity. Sugar Tech. 2022, 8, 15–31. [Google Scholar] [CrossRef]
- Vivas, A.; Marulanda, A.; Ruiz-Lozano, J.M.; Barea, J.M.; Azcón, R. Influence of a Bacillus sp. on physiological activities of two arbuscular mycorrhizal fungi and on plant responses to PEG-induced drought stress. Mycorrhiza 2003, 13, 249–256. [Google Scholar] [CrossRef]
- Mahmood, S.; Daur, I.; Hussain, M.B.; Nazir, Q.; Al-Solaimani, S.G.; Ahmad, S.; Bakhashwain, A.A.; Elsafor, A.K. Silicon application and rhizobacterial inoculation regulate mung bean response to saline water irrigation. Clean–Soil Air Water 2017, 45, 1600436. [Google Scholar] [CrossRef]
- Habib, S.H.; Kausar, H.; Saud, H.M. Plant growth-promoting rhizobacteria enhance salinity stress tolerance in okra through ROS-scavenging enzymes. Biomed Res. Int. 2016, 2016, 6284547. [Google Scholar] [CrossRef]
- Tanaka, A.; Ito, H.; Tanaka, R.; Tanaka, N.K.; Yoshida, K.; Okada, K. Chlorophyll a oxygenase (CAO) is involved in chlorophyll b formation from chlorophyll a. Proc. Natl. Acad. Sci. USA 1998, 95, 12719–12723. [Google Scholar] [CrossRef]
- Kang, M.C.; Kim, S.Y.; Kim, Y.T.; Kim, E.A.; Lee, S.H.; Ko, S.C.; Wijesinghe, W.A.; Samarakoon, K.W.; Kim, Y.S.; Cho, J.H.; et al. In vitro and in vivo antioxidant activities of polysaccharide purified from aloe vera (Aloe barbadensis) gel. Carbohydr. Polym. 2014, 99, 365–371. [Google Scholar] [CrossRef]
- Paczkowska, M.; Kozlowska, M.; Golinski, P. Oxidative stress enzyme activity in Lemna minor L. exposed to cadmium and lead. Acta Biol. Crac. 2007, 49, 33–37. [Google Scholar]
- Scandalios, J.G. Oxygen stress and superoxide dismutases. Plant Physiol. 1993, 101, 7. [Google Scholar] [CrossRef] [PubMed]
- Sharma, P.; Jha, A.B.; Dubey, R.S.; Pessarakli, M. Reactive oxygen species, oxidative damage, and antioxidative defense mechanism in plants under stressful conditions. J. Bot. 2012, 2012, 217037. [Google Scholar] [CrossRef]
- Patterson, W.R.; Poulos, T.L. Crystal structure of recombinant pea cytosolic ascorbate peroxidase. Biochemistry 1995, 34, 4331–4341. [Google Scholar] [CrossRef] [PubMed]
- Iqbal, N.; Umar, S.; Khan, N.A.; Corpas, F.J. Nitric oxide and hydrogen sulfide coordinately reduce glucose sensitivity and decrease oxidative stress via ascorbate-glutathione cycle in heat-stressed wheat (Triticum aestivum L.) plants. Antioxidants 2021, 10, 108. [Google Scholar] [CrossRef] [PubMed]
- Li, H.; Qiu, Y.; Yao, T.; Ma, Y.; Zhang, H.; Yang, X. Effects of PGPR microbial inoculants on the growth and soil properties of Avena sativa, Medicago sativa, and Cucumis sativus seedlings. Soil Tillage Res. 2020, 199, 104577. [Google Scholar] [CrossRef]
- Zarei, T.; Moradi, A.; Kazemeini, S.A.; Akhgar, A.; Rahi, A.A. The role of ACC deaminase producing bacteria in improving sweet corn (Zea mays L. var saccharata) productivity under limited availability of irrigation water. Sci. Rep. 2020, 10, 20361. [Google Scholar] [CrossRef]
- Ali, B.; Wang, X.; Saleem, M.H.; Hafeez, A.; Afridi, M.S.; Khan, S.; Ullah, I.; Amaral Júnior, A.T.; Alatawi, A.; Ali, S. PGPR-mediated salt tolerance in maize by modulating plant physiology, antioxidant defense, compatible solutes accumulation and bio-surfactant producing genes. Plants 2022, 11, 345. [Google Scholar] [CrossRef]
- Sehar, Z.; Masood, A.; Khan, N.A. Nitric oxide reverses glucose-mediated photosynthetic repression in wheat (Triticum aestivum L.) under salt stress. Environ. Exp. Bot. 2019, 161, 277–289. [Google Scholar] [CrossRef]
- Rather, B.A.; Mir, I.R.; Gautam, H.; Majid, A.; Anjum, N.A.; Masood, A.; Khan, N.A. Appraisal of functional significance of sulfur assimilatory products in plants under elevated metal accumulation. Crop. Pasture Sci. 2022, 73, 573–584. [Google Scholar] [CrossRef]
- Sofy, M.R.; Aboseidah, A.A.; Heneidak, S.A.; Ahmed, H.R. ACC deaminase containing endophytic bacteria ameliorate salt stress in Pisum sativum through reduced oxidative damage and induction of antioxidative defense systems. Environ. Sci. Pollut. Res. 2021, 28, 40971–40991. [Google Scholar] [CrossRef]
- Iqbal, N.; Umar, S.; Khan, N.A.; Khan, M.I. A new perspective of phytohormones in salinity tolerance: Regulation of proline metabolism. Environ. Exp. Bot. 2014, 100, 34–42. [Google Scholar] [CrossRef]
- Parmar, P.; Kumari, N.; Sharma, V. Structural and functional alterations in photosynthetic apparatus of plants under cadmium stress. Bot Stud. 2013, 54, 45. [Google Scholar] [CrossRef] [PubMed]
- Garg, N.; Singh, S. Mycorrhizal inoculations and silicon fortifications improve rhizobial symbiosis, antioxidant defense, trehalose turnover in pigeon pea genotypes under cadmium and zinc stress. Plant Growth Regul. 2018, 86, 105–119. [Google Scholar] [CrossRef]
- Yan, K.; Shao, H.; Shao, C.; Chen, P.; Zhao, S.; Brestic, M.; Chen, X. Physiological adaptive mechanisms of plants grown in saline soil and implications for sustainable saline agriculture in coastal zone. Acta Physiol. Plant 2013, 35, 2867–2878. [Google Scholar] [CrossRef]
- Tang, W.; Sun, J.; Liu, J.; Liu, F.; Yan, J.; Gou, X.; Lu, B.R.; Liu, Y. RNAi-directed downregulation of betaine aldehyde dehydrogenase 1 (OsBADH1) results in decreased stress tolerance and increased oxidative markers without affecting glycine betaine biosynthesis in rice (Oryza sativa). Plant Mol. Biol. 2014, 86, 443–454. [Google Scholar] [CrossRef]
- Stobrawa, K.; Lorenc-Plucińska, G. Changes in carbohydrate metabolism in fine roots of the native European black poplar (Populus nigra L.) in a heavy-metal-polluted environment. Sci. Total Environ. 2007, 373, 157–165. [Google Scholar] [CrossRef]
- Shilev, S. Plant-growth-promoting bacteria mitigating soil salinity stress in plants. Appl. Sci. 2020, 10, 7326. [Google Scholar] [CrossRef]
- Bal, H.B.; Nayak, L.; Das, S.; Adhya, T.K. Isolation of ACC deaminase producing PGPR from rice rhizosphere and evaluating their plant growth promoting activity under salt stress. Plant Soil 2013, 366, 93–105. [Google Scholar] [CrossRef]
- Barnawal, D.; Maji, D.; Bharti, N.; Chanotiya, C.S.; Kalra, A. ACC deaminase-containing Bacillus subtilis reduces stress ethylene-induced damage and improves mycorrhizal colonization and rhizobial nodulation in Trigonella foenum-graecum under drought stress. J. Plant Growth Regul. 2013, 32, 809–822. [Google Scholar] [CrossRef]
- Glick, B.R. Bacteria with ACC deaminase can promote plant growth and help to feed the world. Microbiol. Res. 2014, 169, 30–39. [Google Scholar] [CrossRef]
- Albacete, A.; Martínez-Andújar, C.R.; Ghanem, M.E.; Acosta, M.; Sánchez-Bravo, J.O.; Asins, M.J.; Cuartero, J.; Lutts, S.; Dodd, I.C.; Pérez-Alfocea, F.R. Rootstock-mediated changes in xylem ionic and hormonal status are correlated with delayed leaf senescence, and increased leaf area and crop productivity in salinized tomato. Plant Cell Environ. 2009, 32, 928–938. [Google Scholar] [CrossRef] [PubMed]
- Saravanakumar, D.; Samiyappan, R. ACC deaminase from Pseudomonas fluorescens mediated saline resistance in groundnut (Arachis hypogea) plants. J. Appl. Microbiol. 2007, 102, 1283–1292. [Google Scholar] [CrossRef] [PubMed]
- Iqbal, N.; Fatma, M.; Gautam, H.; Sehar, Z.; Rasheed, F.; Khan, M.I.; Sofo, A.; Khan, N.A. Salicylic acid increases photosynthesis of drought grown mustard plants effectively with sufficient-N via regulation of ethylene, abscisic acid, and nitrogen-use efficiency. J. Plant Growth Regul. 2022, 41, 1966–1977. [Google Scholar] [CrossRef]
- Li, C.H.; Wang, G.; Zhao, J.L.; Zhang, L.Q.; Ai, L.F.; Han, Y.F.; Sun, D.Y.; Zhang, S.W.; Sun, Y. The receptor-like kinase SIT1 mediates salt sensitivity by activating MAPK3/6 and regulating ethylene homeostasis in rice. Plant Cell. 2014, 26, 2538–2553. [Google Scholar] [CrossRef]
- Steffens, B. The role of ethylene and ROS in salinity, heavy metal, and flooding responses in rice. Front. Plant Sci. 2014, 5, 685. [Google Scholar] [CrossRef]
- Fatma, M.; Asgher, M.; Iqbal, N.; Rasheed, F.; Sehar, Z.; Sofo, A.; Khan, N.A. Ethylene signaling under stressful environments: Analyzing collaborative knowledge. Plant. 2022, 11, 2211. [Google Scholar] [CrossRef] [PubMed]
- Abbaoui, B.; Lucas, C.R.; Riedl, K.M.; Clinton, S.K.; Mortazavi, A. Cruciferous vegetables, isothiocyanates, and bladder cancer prevention. Mol. Nutr. Food Res. 2018, 62, 1800079. [Google Scholar] [CrossRef]
- Mahmud, I.; Shahria, N.; Yeasmin, S.; Iqbal, A.; Mukul, E.H.; Gain, S.; Shilpi, J.A.; Islam, M.K. Ethnomedicinal, phytochemical and pharmacological profile of a mangrove plant Ceriops decandra GriffDin Hou. J. Complement. Integr. Med. 2018, 16, 20170129. [Google Scholar] [CrossRef]
- Shankar, S.; Segaran, G.; Sundar, R.D.; Settu, S.; Sathiavelu, M. Brassicaceae-A classical review on its pharmacological activities. Int. J. Pharm. Sci. Rev. Res. 2019, 55, 107–113. [Google Scholar]
- Valifard, M.; Mohsenzadeh, S.; Kholdebarin, B.; Rowshan, V. Effects of salt stress on volatile compounds, total phenolic content and antioxidant activities of Salvia mirzayanii. South Afr. J. Bot. 2014, 93, 92–97. [Google Scholar] [CrossRef]
- AbdElgawad, H.; Zinta, G.; Hegab, M.M.; Pandey, R.; Asard, H.; Abuelsoud, W. High salinity induces different oxidative stress and antioxidant responses in maize seedlings organs. Front. Plant Sci. 2016, 7, 276. [Google Scholar] [CrossRef] [PubMed]
- Brunetti, C.; Di Ferdinando, M.; Fini, A.; Pollastri, S.; Tattini, M. Flavonoids as antioxidants and developmental regulators: Relative significance in plants and humans. Int. J. Mol. Sci. 2013, 14, 3540–3555. [Google Scholar] [CrossRef] [PubMed]
- Winkel-Shirley, B. Biosynthesis of flavonoids and effects of stress. Curr. Opin. Plant Biol. 2002, 5, 218–223. [Google Scholar] [CrossRef] [PubMed]
- Kandoliya, U.K.; Vakharia, D.N. Induced resistance and phenolic acid accumulation in biological control of chickpea wilt by Pseudomonasfluorescens. Asian J. Biol. Sci. 2013, 8, 184–188. [Google Scholar]
- Warwate, S.I.; Kandoliya, U.K.; Bhadja, N.V.; Golakiya, B.A. The effect of Plant Growth Promoting Rhizobacteria (PGPR) on biochemical parameters of coriander (Coriandrum sativum L.) seedling. Int. J. Curr. Microbiol. Appl. Sci. 2017, 6, 1935–1944. [Google Scholar]
- Yuan, G.; Wang, X.; Guo, R.; Wang, Q. Effect of salt stress on phenolic compounds, glucosinolates, myrosinase and antioxidant activity in radish sprouts. Food Chem. 2010, 121, 1014–1019. [Google Scholar] [CrossRef]
- Aziz, M.; Nadipalli, R.K.; Xie, X.; Sun, Y.; Surowiec, K.; Zhang, J.L.; Paré, P.W. Augmenting sulfur metabolism and herbivore defense in Arabidopsis by bacterial volatile signaling. Front. Plant Sci. 2016, 7, 458. [Google Scholar] [CrossRef]
- Schoonhoven, L.M.; Van Loon, B.; van Loon, J.J.; Dicke, M. Insect-Plant Biology; Oxford University Press: Oxford, UK, 2005. [Google Scholar]
- Chowdhury, P. Glucosinolates and Its Role in Mitigating Abiotic and Biotic Stress in Brassicaceae. In Plant Stress Physiology—Perspectives in Agriculture; Hasanuzzaman, M., Nahar, K., Eds.; Intech Open: London, UK, 2022. [Google Scholar]
- Brock, A.K.; Berger, B.; Mewis, I. Impact of the PGPB Enterobacter radicincitans DSM 16656 on Growth, Glucosinolate Profile, and Immune Responses of Arabidopsis thaliana. Microb. Ecol. 2013, 65, 661–670. [Google Scholar] [CrossRef]

| Bacterial Strains | Gram Reaction | Cell Shape | IAA (µg mL−1) | ACC Deaminase Production (µM α Ketobutyrate mg−1 Protein h−1) | Siderophore Production CAS Agar Plate Assay Zone Formation and Zone Production in (mm) | Ammonia Production | HCN Production | Phosphate Solubilisation |
|---|---|---|---|---|---|---|---|---|
| Pseudomonas fluorescens | Gram-negative | Short rod shaped | 86.8 ± 1.79 | 210 ± 0.42 | +ve 21.4 ± 1.3 | + | + | + |
| Azotobacter chroococcum | Gram-negative | Oval shaped | 79.4 ± 2.17 | 193 ± 1.65 | +ve 13.2 ± 1.7 | + | + | + |
| Treatment | Root Length (cm) | Shoot Length (cm) | Height of Plant (cm) | Root Biomass (g Plant−1) | Shoot Biomass (g Plant−1) | No. of Leaves | Leaf Area (cm2) | ||
|---|---|---|---|---|---|---|---|---|---|
| Fresh | Dry | Fresh | Dry | ||||||
| Control | 6.667 ± 0.37 d | 10.23 ± 0.77 d | 16.900 ± 0.84 d | 0.08 ± 0.00 4 d | 0.017 ± 0.001 c | 0.849 ± 0.065 d | 0.110 ± 0.012 d | 8.333 ± 4.49 d | 7.10 ± 0.63 d |
| 100 mM NaCl | 3.530 ± 0.281 g | 6.633 ± 0.58 g | 10.163 ± 0.62 g | 0.04 ± 0.002 g | 0.009 ± 0.0009 g | 0.38 ± 0.0335 g | 0.047 ± 0.0056 g | 3.667 ± 1.700 g | 4.63 ± 0.105 g |
| PGPR1 | 7.683 ± 0.56 b | 13.40 ± 0.94 b | 21.063 ± 0.99 b | 0.10 ± 0.006 b | 0.027 ± 0.002 b | 1.287 ± 0.046 b | 0.203 ± 0.019 b | 12.667 ± 3.300 b | 10.6 ± 0.304 b |
| PGPR2 | 7.013 ± 0.486 c | 12.1 ± 0.85 c | 20.003 ± 0.91 c | 0.09 ± 0.005 c | 0.012 ± 0.001 c | 1.03 ± 0.071 c | 0.172 ± 0.0176 c | 10.000 ± 2.449 c | 9.19 ± 0.961 c |
| PGPR (1 + 2) | 8.560 ± 0.662 a | 15.90 ± 0.99 a | 24.460 ± 1.055 a | 0.19 ± 0.008 a | 0.038 ± 0.003 a | 1.56 ± 0.072 a | 0.357 ± 0.0246 a | 17.333 ± 2.494 a | 14.03 ± 0.74 a |
| 100 mM NaCl + PGPR1 | 5.220 ± 0.362 e | 8.067 ± 0.66 e | 13.287 ± 0.71 e | 0.07 ± 0.004 e | 0.013 ± 0.001 c | 0.654 ± 0.07 e | 0.077 ± 0.0064 e | 6.000 ± 2.160 e | 5.810 ± 0.76 e |
| 100 mM NaCl + PGPR2 | 4.633 ± 0.415 f | 7.100 ± 0.58 f | 11.933 ± 0.67 f | 0.06 ± 0.003 f | 0.010 ± 0.001 d | 0.51 ± 0.057 f | 0.064 ± 0.0074 f | 4.667 ± 3.859 f | 4.83 ± 0.348 f |
| 100 mM NaCl + PGPR (1 + 2) | 6.300 ± 0.505 d | 9.167 ± 0.72 d | 16.07 ± 0.92 d | 0.08 ± 0.04 d | 0.016 ± 0.002 c | 0.807 ± 0.041 d | 0.102 ± 0.09 d | 7.667 ± 4.497 d | 6.797 ± 0.9 d |
| Treatments | Total Glucosinolate Content Total Glucosinolate (μmol g−1 FW) | Total Phenolic Content (mg GAE g−1 FW) | Total Flavonoid Content (mg Rutin g−1 FW) | Carotenoids (mg g−1 FW) |
|---|---|---|---|---|
| Control | 19.189 ± 1.18 g | 07.211 ± 0.33 f | 08.799 ± 0.43 f | 0.885 ± 0.045 d |
| Salt | 31.204 ± 2.12 a | 10.415 ± 0.76 e | 12.056 ± 0.82 e | 0.408 ± 0.011 g |
| PGPR1 | 24.538 ± 1.44 e | 13.158 ± 0.84 c | 15.694 ± 0.91 b | 1.052 ± 0.090 b |
| PGPR2 | 23.746 ± 1.26 f | 12.189 ± 0.73 d | 13.444 ± 0.77 d | 0.949 ± 0.082 c |
| PGPR(1 + 2) | 27.906 ± 1.69 c | 15.416 ± 1.09 a | 18.653 ± 1.16 a | 1.217 ± 0.181 a |
| Salt + PGPR1 | 25.608 ± 1.53 d | 12.025 ± 0.73 d | 14.883 ± 0.79 c | 0.610 ± 0.061 e |
| Salt + PGPR2 | 24.142 ± 1.31 e | 10.480 ± 0.81 e | 13.606 ± 0.71 d | 0.526 ± 0.033 f |
| Salt + PGPR(1 + 2) | 28.817 ± 1.78 b | 14.204 ± 0.94 b | 15.347 ± 1.01 b | 0.838 ± 0.043 d |
Disclaimer/Publisher’s Note: The statements, opinions and data contained in all publications are solely those of the individual author(s) and contributor(s) and not of MDPI and/or the editor(s). MDPI and/or the editor(s) disclaim responsibility for any injury to people or property resulting from any ideas, methods, instructions or products referred to in the content. |
© 2023 by the authors. Licensee MDPI, Basel, Switzerland. This article is an open access article distributed under the terms and conditions of the Creative Commons Attribution (CC BY) license (https://creativecommons.org/licenses/by/4.0/).
Share and Cite
Khan, V.; Umar, S.; Iqbal, N. Palliating Salt Stress in Mustard through Plant-Growth-Promoting Rhizobacteria: Regulation of Secondary Metabolites, Osmolytes, Antioxidative Enzymes and Stress Ethylene. Plants 2023, 12, 705. https://doi.org/10.3390/plants12040705
Khan V, Umar S, Iqbal N. Palliating Salt Stress in Mustard through Plant-Growth-Promoting Rhizobacteria: Regulation of Secondary Metabolites, Osmolytes, Antioxidative Enzymes and Stress Ethylene. Plants. 2023; 12(4):705. https://doi.org/10.3390/plants12040705
Chicago/Turabian StyleKhan, Varisha, Shahid Umar, and Noushina Iqbal. 2023. "Palliating Salt Stress in Mustard through Plant-Growth-Promoting Rhizobacteria: Regulation of Secondary Metabolites, Osmolytes, Antioxidative Enzymes and Stress Ethylene" Plants 12, no. 4: 705. https://doi.org/10.3390/plants12040705
APA StyleKhan, V., Umar, S., & Iqbal, N. (2023). Palliating Salt Stress in Mustard through Plant-Growth-Promoting Rhizobacteria: Regulation of Secondary Metabolites, Osmolytes, Antioxidative Enzymes and Stress Ethylene. Plants, 12(4), 705. https://doi.org/10.3390/plants12040705

